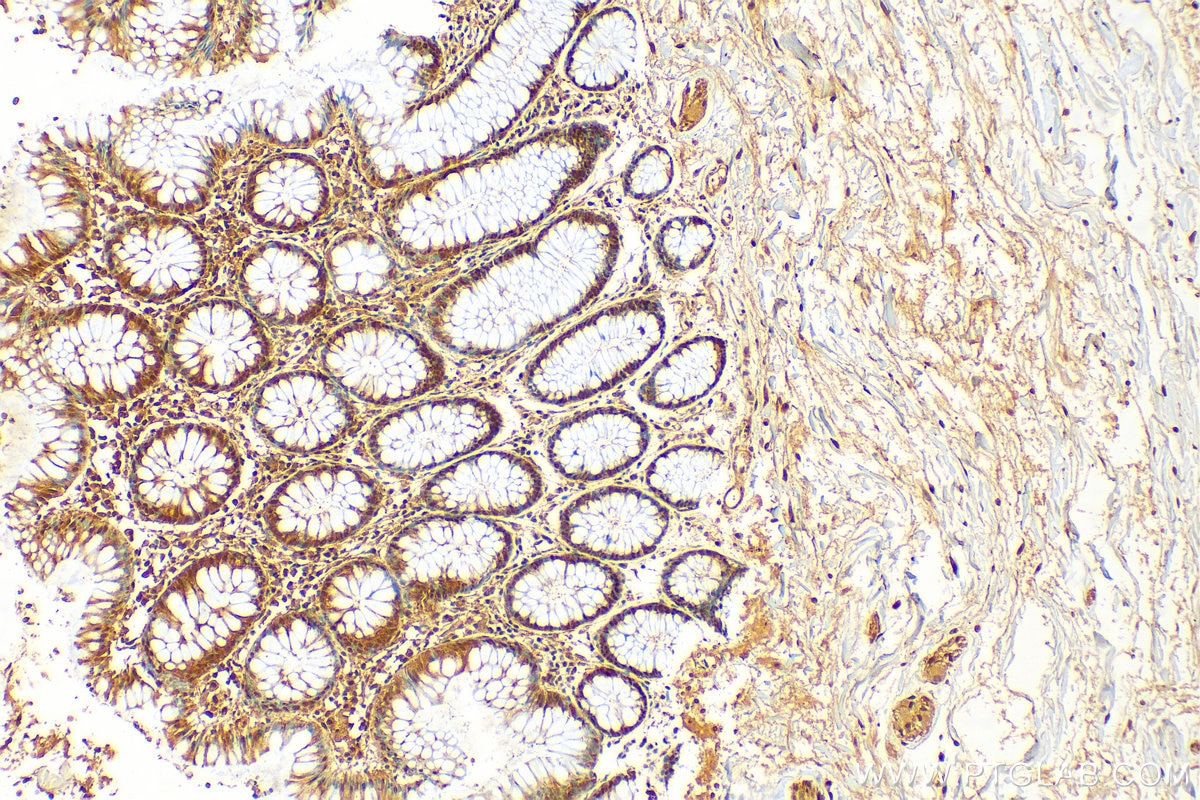
Immunohistochemistry (IHC) staining of human colon tissue using MTAP Polyclonal antibody (11475-1-AP)
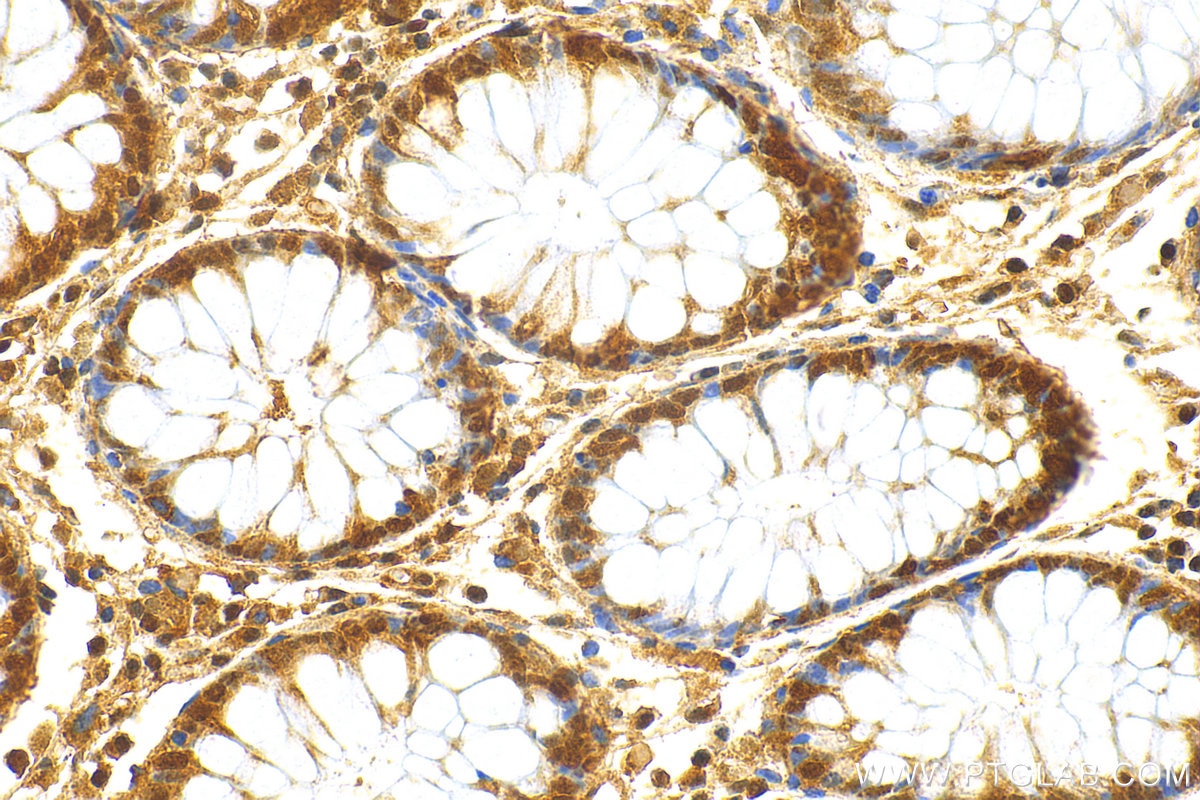
Immunohistochemistry (IHC) staining of human colon tissue using MTAP Polyclonal antibody (11475-1-AP)

Validation Data Gallery
Tested Applications
| Positive WB detected in | HEK-293 cells, HCT 116 cells, Raji cells, HT-29 cells, HeLa cells, NIH/3T3 cells, C6 cells, mouse heart tissue |
| Positive IHC detected in | human colon cancer tissue, human colon tissue, human liver cancer tissue, mouse heart tissue, mouse skin tissue, rat skin tissue Note: suggested antigen retrieval with TE buffer pH 9.0; (*) Alternatively, antigen retrieval may be performed with citrate buffer pH 6.0 |
| Positive IF/ICC detected in | HeLa cells |
Recommended dilution
| Application | Dilution |
|---|---|
| Western Blot (WB) | WB : 1:2000-1:12000 |
| Immunohistochemistry (IHC) | IHC : 1:300-1:1200 |
| Immunofluorescence (IF)/ICC | IF/ICC : 1:50-1:500 |
| It is recommended that this reagent should be titrated in each testing system to obtain optimal results. | |
| Sample-dependent, Check data in validation data gallery. | |
Published Applications
| KD/KO | See 2 publications below |
| WB | See 13 publications below |
| IHC | See 22 publications below |
Product Information
11475-1-AP targets MTAP in WB, IHC, IF/ICC, ELISA applications and shows reactivity with human, mouse, rat samples.
| Tested Reactivity | human, mouse, rat |
| Cited Reactivity | human, mouse, rat |
| Host / Isotype | Rabbit / IgG |
| Class | Polyclonal |
| Type | Antibody |
| Immunogen |
CatNo: Ag2051 Product name: Recombinant human MTAP protein Source: e coli.-derived, PGEX-4T Tag: GST Domain: 1-154 aa of BC018625 Sequence: MASGTTTTAVKIGIIGGTGLDDPEILEGRTEKYVDTPFGKPSDALILGKIKNVDCILLARHGRQHTIMPSKVNYQANIWALKEEGCTHVIVTTACGSLREEIQPGDIVIIDQFIDSHVRRACFPFTFHHDCFQRPPQKPSRSHCVSCATCRTMS 相同性解析による交差性が予測される生物種 |
| Full Name | methylthioadenosine phosphorylase |
| Calculated molecular weight | 283 aa, 31 kDa |
| Observed molecular weight | 31 kDa |
| GenBank accession number | BC018625 |
| Gene Symbol | MTAP |
| Gene ID (NCBI) | 4507 |
| RRID | AB_2147094 |
| Conjugate | Unconjugated |
| Form | |
| Form | Liquid |
| Purification Method | Antigen affinity purification |
| UNIPROT ID | Q13126 |
| Storage Buffer | PBS with 0.02% sodium azide and 50% glycerol{{ptg:BufferTemp}}7.3 |
| Storage Conditions | Store at -20°C. Stable for one year after shipment. Aliquoting is unnecessary for -20oC storage. |
Background Information
MTAP is a 5-deoxy-5-methylthioadenosine (MTA) phosphorylase, converting MTA to salvageable intermediates including adenine and 5-methylthioribose-1-phosphate. MTAP is abundant in normal cells, but it is frequently found to be deleted in a variety of cancers. Its deficiency is common in cancer cell lines as well as in primary leukemia, lung cancer, melanoma, bladder cancer, gliomas and breast cancer.
Protocols
| Product Specific Protocols | |
|---|---|
| IF protocol for MTAP antibody 11475-1-AP | Download protocol |
| IHC protocol for MTAP antibody 11475-1-AP | Download protocol |
| WB protocol for MTAP antibody 11475-1-AP | Download protocol |
| Standard Protocols | |
|---|---|
| Click here to view our Standard Protocols |
Publications
| Species | Application | Title |
|---|---|---|
J Clin Invest SHARPIN-mediated regulation of protein arginine methyltransferase 5 controls melanoma growth. | ||
Nat Commun MTAP deficiency creates an exploitable target for antifolate therapy in 9p21-loss cancers. | ||
Nat Commun Pharmacological polyamine catabolism upregulation with methionine salvage pathway inhibition as an effective prostate cancer therapy. | ||
Clin Cancer Res Homozygous deletion of MTAP gene as a poor prognosticator in gastrointestinal stromal tumors. | ||
Oncoimmunology Suppressive effects of tumor cell-derived 5'-deoxy-5'-methylthioadenosine on human T cells. | ||
J Pathol Methylthioadenosine phosphorylase and activated insulin-like growth factor-1 receptor/insulin receptor: potential therapeutic targets in chordoma. |